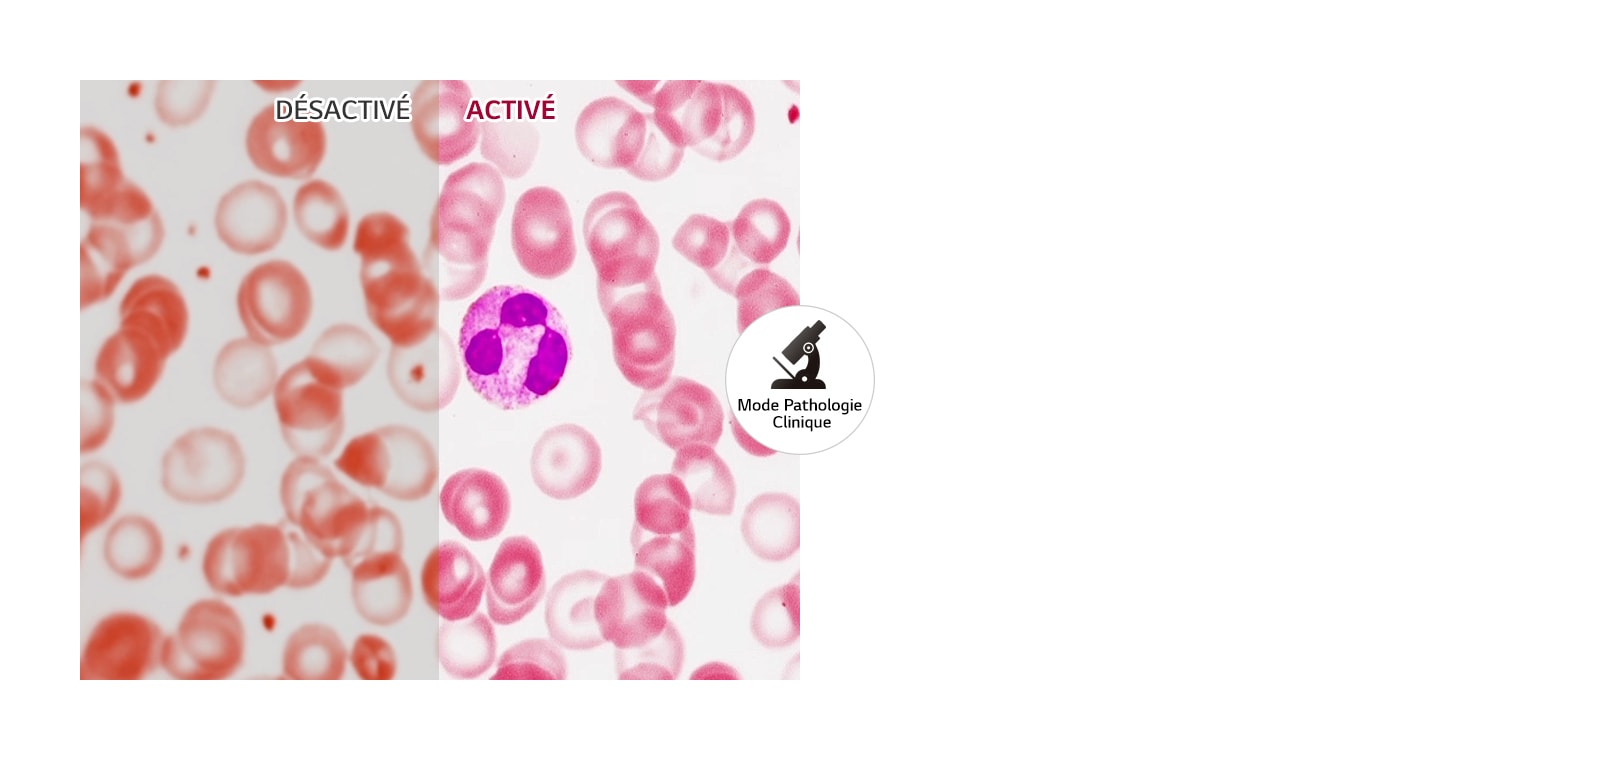
32HL512D-B

AJOUTER À LA LISTE DE SOUHAITS
Ajoutez des articles à votre liste de souhaits MYLG
Voir la Liste de souhaits
Archivés
32HL512D-B
Copier le nom du modèle
Moniteur de Diagnostic LG 8MP
*titleText*
Le nom du modèle a été copié
Voir le revendeur pour la détermination du prix
Vente en quantité limitée
Quantité disponible
*quantity* ea
-
Prix du produit(32HL512D-B)
€*rPrice*€*rPromoPrice**discountPDPMsg*Prix des membres LG(32HL512D-B)€*rMemberPrice*€*rMembershipPrice**discountPDPMsg*vip-price-message(32HL512D-B)€*rPrice*€*rVipPrice**discountPDPMsg*OBS_CHEAPERPRICE_MSG €*cheaperPrice*
Prix des membres LG€*rMembershipPrice**rWelcomePriceDescription**rWelcomePriceTooltip*
€*rWelcomePrice*
Total
MSRP
€*improveTotalPrice*
MSRP
€
Voir le revendeur pour la détermination du prix
OBS_MEMBERSHIP_MSG €*recommendedMembershipPrice*
┗ *modelName*
€*discountedPrice*
*userFriendlyName*
bundle-unable-text
€*discountedPrice*
Save €*discountPrice*
component-protectYour
0 component-selectedItems
*modelName*
€*rPrice*.*rPriceCent*
€*rPromoPrice*.*rPromoPriceCent*
*discountMsg*
OBS_LOWEST_PRICE_MARK_MSG
*retailerPricingText*
*modelName*
€*rPrice*.*rPriceCent*
€*rPromoPrice*.*rPromoPriceCent*
*discountMsg*
OBS_LOWEST_PRICE_MARK_MSG
*retailerPricingText*
Moniteur de Diagnostic LG 8MP
L
-
- Rapport d'aspect
- 16:9
- Luminosité (typ.)
- 450cd/m²
-
- Gamme de couleurs en bits
- 10bit (8bit+FRC)
- Espace colorimétrique
- DCI-P3 98%(CIE1976)
-
- Rapport de contraste (typ.)
- 1300:1
- Type de panneau
- IPS
-
- Résolution
- 3840x2160
- Temps de réponse (GTG)
- 14 ms (réglage: désactivé), 5 ms (réglage: plus rapide)
-
- taille (pouces)
- 31.5
- Revêtement d'écran
- Anti-éblouissement, 3H
-
- Angle de vue (CR≥10)
- 178° (gauche / droite), 178° (haut / Nonr)
Display
-
- Backlight Dimming Technology
- Global Dimming
- Backlight Technology
- LED
-
- Backlight Type
- Edge
- Brightness (Min.)
- 360 cd/m²
-
- Brightness (Stabilization)
- 250 (Clinical mode setting) / 350 (Dignostic mode setting) cd/m²
- Color Depth (Number of Colors)
- 1.07B
-
- Contrast Ratio with DFC
- Mega
- Peak Brightness (Min.)
- 360 cd/m² (Peak)
-
- Peak Brightness (Typ.)
- 450 cd/m² (Peak)
- Pixel Pitch (H x V)
- 0.18159mm x 0.18159mm
-
- Size (cm)
- 80.0051
Les fonctions
-
- Stabilisation de la luminosité
- Oui
- Stabilisation du noir
- Oui
-
- Calibrage matériel
- Oui (PerfectLum)
- Certifié DICOM
- Oui
-
- Température de couleur
-
6500K / 7500K / 9300K
Manuel (5000K ~ 10000K)
- Flicker Safe
- Oui
-
- HDR 10
- Oui
- Effet HDR
- Oui
-
- PBP
- Oui (2PBP)
- PIP
- Oui
-
- Mode multi-résolution
- Oui (8MP/6MP/4MP)
- Mode pathologie
- Oui
-
- Mode de lecture
- Oui
- Mode Light Box
- Oui
-
- Consommation d'énergie intelligente
- Oui
- Super Resolution+
- Oui
FEATURE
-
- Factory Calibration
- Oui (Delta E<5, Gamma 1.8~2.6/DICOM curve)
- Nano IPS™ Technology
- Oui
-
- OSD Language
- 17 Language
- Picture Mode
- (SDR) Custom, Mono, Pathology, Reader, Vivid, HDR Effect, DICOM (Clinical), DICOM (Diagnostic), Calibration 1, Calibration 2, (HDR) Custom, Vivid, Standard
-
- Uniformity
- Oui
- Wide Color Gamut
- Oui
Applications
-
- Dual Controller
- Oui
- Qubyx
- Oui
SW Application
-
- OnScreen Control (LG Screen Manager)
- Oui
Connectivité
-
- DisplayPort
- Oui (2ea)
- DP (HDCP Version)
- 2.2
-
- DP (Max. Resolution at Hz)
- 3840 x 2160 @60Hz
- DP (H-Frequency)
- 30~135 kHz
-
- DP (V Frequency)
- 56~61 Hz
- DP Version
- 1.4
-
- HDMI
- Oui (1ea)
- DVI
- OUI (1ea)
-
- HDMI (HDCP Version)
- 2.2
- HDMI (Max. Resolution at Hz)
- 3840 x 2160 @60Hz
-
- HDMI (H Frequency)
- 30~135 kHz
- HDMI (V Frequency)
- 56~61 Hz
-
- HDMI Version
- 2.0
- USB Downstream
- Oui (2ea/ver2.0)
-
- USB Upstream
- Oui (1ea/ver2.0)
- [Location]
- Rear
Consommation
-
- AC Input
- 100-240Vac, 50/60Hz
- DC Output
- 19V, 3.42A
-
- Consommation d'énergie (sortie CC)
- Moins de 0.3W
- Consommation d'énergie (max.)
- 65W
-
- Type d'adaptateur
- Adaptateur externe
Power
-
- Power Consumption (Sleep Mode)
- Less than 0.5W
Mechanical
-
- Base Detchable
- Oui
- Color (Back Cover)
- Black
-
- Color (Front Cabinet)
- Black
- Color (Middle Cabinet)
- Black
-
- Color (Stand Base)
- Black
- Color (Stand Body)
- Black
Propriétés mécaniques
-
- Conception sans bordure
- Normal
- Pied d'options de réglage
- Inclinaison / hauteur / rotation
-
- Position la plus basse
- 85.3mm
- Gamme de hauteur
- 110mm
-
- Support OneClick
- Oui
- Rotatif
- Oui (±90°)
-
- Inclinaison
- Oui (-5°~20˚)
- Montage mural
- 100 x 100 mm
Dimensions
-
- Dimensions de l'emballage (W x L x H)
- 838 x 553 x 240mm
- Dimensions avec support (W x L x H)
- 718.2 x 590.0 x 231.2mm
-
- Dimensions sans support (W x L x H)
- 718.2 x 414.3 x 45.1mm
- Pallette (20ft/40ft/40ft HC)
- 144EA/336EA/560EA
-
- Poids dans l'emballage
- 11.4kg (25.1lb)
- Poids avec base
- 7.3kg (16.1lb)
-
- Poids sans base
- 5.9kg (13lb)
Normes médicales
-
- IEC (IEC 60601-1 / IEC 60601-1-2)
- Oui
- EN (EN 60601-1 / EN 60601-1-2)
- Oui
-
- IEC (IEC 60950-1 / IEC 55032, 55024)
- Oui
- EN (EN 60950-1 / EN 55032, 55024)
- Oui
-
- cUL (ANSI/AAMI ES 60601-1, CSA CAN/CSA-C22.2 Non. 60601-1)
- Oui
- FCC (FCC part 15 Class A)
- Oui
-
- FDA
- 510 (k) (Class II)
- ISO13485
- Oui
-
- GMP
- Oui
- KGMP
- Oui
-
- RoHS
- Oui
- REACH
- Oui
-
- WEEE
- Oui
- MFDS
- Oui
Accessoires
-
- Adaptateur
- Oui
- Adapter (Color)
- Black
-
- Calibration Report (Paper)
- Oui
- Display Port
- Oui
-
- Display Port (Color/Length)
- Black / 1.8m
- HDMI
- Oui
-
- HDMI (Color/Length)
- Black / 1.8m
- Power Cord
- Oui
-
- Power Cord (Color/Length)
- Black / 1.8m
Informations sur la conformité
- The safety information for accessories is included with the safety information for the product and is not provided separately.
- De veiligheidsinformatie voor accessoires is opgenomen bij de veiligheidsinformatie voor het product en wordt niet afzonderlijk verstrekt.
Les informations de sécurité relatives aux accessoires sont incluses avec les informations de sécurité du produit et ne sont pas fournies séparément. - Pour en savoir plus sur la manière dont ce produit traite les données et sur vos droits en tant qu’utilisateur, veuillez consulter « Couverture des données et spécifications » à l’adresse LG Privacy.
Avis d'Utilisateurs
DES QUESTIONS ? LAISSEZ NOUS VOUS AIDER
Voir 32HL512D-B Support Produit
-
Demande de réparation Bénéficiez de notre service de réparation sur vos produits En Savoir Plus
-
Aide & Solutions les astuces d'entretien et le guide de depannage étape par étape. En Savoir Plus
-
Manuels Obtenez les dernières mises à jour des manuels En Savoir Plus
-
Tutoriels vidéos Apprenez à connaitre votre produit Lgsur le bout des doigts En Savoir Plus
-
Planifier une intervention à domicile En Savoir Plus
-
Etat d'avancement de réparation Suivez en direct l'avancement de votre réparation En Savoir Plus
-
Trouver un centre de services agréé Localisez le centre de services le plus proche de chez vous En Savoir Plus
-
Garantie Information relatives à la période de garantie et aux garanties particulières En Savoir Plus
Choisissez simplement une l'assistance désirée parmi les icônes ci-dessous
-
E-Mail Envoyez un message électronique au service clients LG
-
Téléphone 00 32 (0)15 200 255
(BE: tarif local; LUX: tarif int.) Lun au Ven 08.30 - 20.00 heures
€*rPrice*.*rPriceCent*
€*rPromoPrice*.*rPromoPriceCent*
*discountMsg*
*retailerPricingText*
OBS_MEMBERSHIP_MSG €*siblingMembershipPrice*
*obsMemberShipLinkEnd*